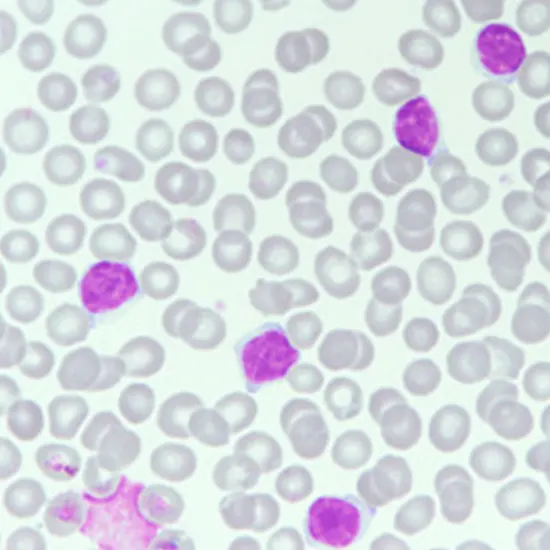

Book Chronic Lymphoproliferative Disorder Advance Appointment Online Near me at the best price in Delhi/NCR from Ganesh Diagnostic. NABL & NABH Accredited Diagnostic centre and Pathology lab in Delhi offering a wide range of Radiology & Pathology tests. Get Free Ambulance & Free Home Sample collection. 24X7 Hour Open. Call Now at 011-47-444-444 to Book your Chronic Lymphoproliferative Disorder Advance at 50% Discount.
Chronic lymphoproliferative disorders are a group of diseases characterized by the overproduction of mature lymphocytes, which are a type of white blood cell. These disorders can be benign (non-cancerous) or malignant (cancerous) and can affect different types of lymphocytes.
The diagnosis of chronic lymphoproliferative disorders typically involves a combination of physical examination, blood tests, imaging studies (such as CT scans or PET scans), and a biopsy of affected tissue to confirm the presence of abnormal lymphocytes.
Several advanced tests can be used to help diagnose and monitor chronic lymphoproliferative disorders, as well as to guide treatment decisions such as fluorescence in situ hybridization (FISH), next-generation sequencing (NGS), Flow cytometry, etc.
Advanced tests such as fluorescence in situ hybridization (FISH), next-generation sequencing (NGS), flow cytometry, and positron emission tomography (PET) scans can help diagnose and monitor CLPDs, as well as guide treatment decisions. Here are some reasons why these tests are done:
Overall, advanced tests are important tools in the diagnosis, treatment, and monitoring of patients with CLPDs, and can help improve patient outcomes by guiding personalized treatment decisions
The types of samples depend on the specific tests to be performed such as
The cost of Chronic Lymphoproliferative Disorder Advance near me in Delhi ranges from INR 15000 to INR 40000
| Test Type | Chronic Lymphoproliferative Disorder Advance |
| Includes | Chronic Lymphoproliferative Disorder Advance (Pathology Test) |
| Preparation | |
| Reporting | Within 24 hours* |
| Test Price |
₹ 6500
|

Early check ups are always better than delayed ones. Safety, precaution & care is depicted from the several health checkups. Here, we present simple & comprehensive health packages for any kind of testing to ensure the early prescribed treatment to safeguard your health.